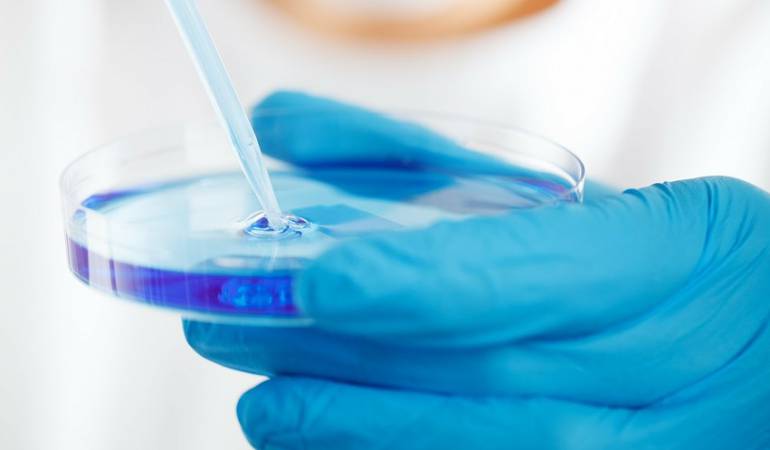

El microbioma: convivimos con 2 kilos de bacterias
Microorganismos que pueden ser decisivos en enfermedades autoinmunes, alergias, problemas glandulares, gastrointestinales, diabetes, artritis, autismo y posiblemente el cáncer.

PublicDomainPictures (CC )
Bogotá
El término “microbioma” se refiere a los billones de bacterias y otros microbios que habitan de forma natural en el intestino. La gran cantidad de enfermedades asociadas a una disbiosis o un desbalance del microbioma hace que sea el tema del momento en la medicina y en la biología. Además estamos rodeados de una “nube” de bacterias.
Enfermedades autoinmunes, alergias, problemas glandulares, problemas gastrointestinales como el síndrome de intestino irritable, el reflujo, la colitis (y otras), la diabetes, la artritis, el autismo, y posiblemente el cáncer se ven afectadas por el micriobioma. Sería más económico en realidad nombrar qué enfermedades no tienen que ver con el microbioma, pero ocurre que cada vez descubrimos nuevas correlaciones, por lo que es arriesgado decir que cualquier enfermedad no tiene que ver con el microbioma o con la inflamación.
Si hemos evolucionado desde el albor de la humanidad con estos microorganismos, ¿por qué es hasta ahora que se han vuelto tan importantes?
1) El uso de antibióticos. El incremento y abuso de antibióticos para controlar todo tipo de infecciones (incluyendo aquellas para las que no son efectivos, como las gripas) en humanos y animales de granja (que consumimos en alimentos) ha hecho que muchas especies de nuestro microbioma “indígena”, por así decirlo, se extinga o esté seriamente amenazadas.
2) Nuestra dieta moderna. La dieta moderna basada en poca fibra y en general en un menor consumo de plantas prebióticas ha hecho mella en nuestro microbioma. A la par, la comida procesada, sustancias que son “como comida” (pero no realmente comida), la comida chatarra, ha limado el camino para que el ecosistema interno sea dominado por bacterias agresivas propensas a la inflamación.
3) El incremento en las cesáreas. No es un secreto que hoy en día algunas mujeres eligen que sus hijos nazcan por cesárea no solo por evitar riesgos sino también por comodidad. Esto es preocupante ya que el microbioma, ese órgano adquirido, se forma justamente cuando el bebé cruza el canal vaginal y se llena de las bacterias de su madre. Estas amorosas bacterias –muchas de ellas lactobacilos– son la primera línea de defensa del organismo y desempeñan papeles protagónicos en la secreción de hormonas y neurotransmisores. Al faltar este feliz ejército, un bebé forma su microbioma de un entorno más agresivo, como el que puede encontrar en un hospital.
4) La disminución de horas netas de lactancia. La otra vía por la que un bebé abastece su microbioma es a través de la leche materna, rica en bifidobacterias, algo que simplemente no tiene sustituto, aunque puede paliarse con probióticos.
Decodificar el genoma humano supuestamente iba convertirse en la segunda revolución pero simplemente no ha dado resultados, pero una revolución del microbioma parece más prometedora. Y es que no podemos cambiar nuestros genes, pero podemos cambiar nuestros microbios.
La mayoría de nuestras enfermedades son provocadas por factores epigenéticos, es decir, producidos por la forma en la que vivimos e interactuamos con nuestro medio ambiente, entre los que podríamos incluir a nuestro microbioma, el cual se puede considerar como un genoma en constante interacción con el medio ambiente. Para ellos parece importante asumir una perspectiva holística en la que se piense no solo en nuestras células humanas cuando nos alimentamos, hacemos ejercicio o tomamos medicamentos, sino también en nuestro microbioma. Esto es un cambio de paradigma de lo antibiótico a lo probiótico y del individualismo evolutivo a una conciencia hologenómica.
Una investigación reciente sugiere que el tamaño de la cintura depende en cierta medida de bacterias específicas que habitan en el intestino. En el estudio, que contó con la participación de unos 900 adultos holandeses, se encontró que algunas bacterias intestinales podrían ayudar a determinar no solo los niveles de grasa corporal, sino también las concentraciones sanguíneas de colesterol HDL y triglicéridos.
El colesterol HDL es el “bueno” que ayuda a mantener un corazón sano; los triglicéridos son otro tipo de grasa en la sangre que, en exceso, pueden contribuir a enfermedades cardíacas.
Microorganismos
Una investigación reciente reveló que los microorganismos hacen mucho más que apoyar una buena digestión: ayudan en todo, desde la función inmune hasta la metabolización de fármacos para la producción de vitaminas, compuestos antiinflamatorios e incluso sustancias químicas que transmiten mensajes entre las células del cerebro.
Los estudios también sugieren que cuando el microbioma carece de diversidad puede contribuir a problemas de salud como la obesidad, el asma y la diabetes tipo 1. En general, los investigadores encontraron 34 tipos de bacterias que se relacionaban con los triglicéridos y los niveles de HDL de la gente, y con el índice de masa corporal (IMC), una medida del peso en relación con la altura.
Los investigadores estimaron que el microbioma intestinal era responsable entre un 4 por ciento y 6 por ciento de la variación en el índice de masa corporal, los niveles de triglicéridos y de HDL del grupo que participó en el estudio. Aún no saben cómo definir un microbioma “saludable”. Pero los estudios sugieren que la vida moderna puede estar disminuyendo la diversidad del microbioma intestinal y que esta falta de diversidad puede relacionare con mayores riesgos de enfermedades.
Las dietas plagadas de alimentos procesados también son responsables. El microbioma intestinal se puede modificar mediante la dieta, a diferencia de la edad, los genes y otros factores de riesgo de enfermedades cardíacas. Por ahora, se sugiere que la gente siga hábitos alimenticios probados, tales como una dieta rica en frutas, verduras, pescado, granos con alto contenido de fibra y otros alimentos “integrales”.
La 'nube microbiana'
Los individuos liberan bacterias en sus alrededores, encuentra un estudio llevado a cabo en una cámara sellada. En un hallazgo que sin duda alarmará a los germófobos de todas partes, los científicos afirman que las personas emiten una "nube microbiana" de bacterias donde quiera que se encuentren. "Esperábamos poder detectar el microbioma humano en el aire que rodea a una persona, pero nos sorprendió hallar que podíamos identificar a la mayoría de ocupantes simplemente mediante muestras de su nube microbiana", comentó el autor del estudio, James Meadow, de la Universidad de Oregón.
Esa colonia de organismos es lo que los científicos han bautizado como "microbioma". Ahora, el estudio de Oregón encuentra que las personas también emiten parte de su microbioma como una especie de niebla que las rodea.
Las especies clave fueron Streptococcus, que por lo general se encuentra en la boca, y gérmenes cutáneos como Propionibacterium y Corynebacterium. Los hallazgos podrían ayudar a mejorar la comprensión sobre cómo se propagan las enfermedades infecciosas, o incluso ofrecer nuevas formas de identificar a los sospechosos de un crimen, apuntaron los investigadores.
Todo nuestro cuerpo, incluyendo nuestra piel, nuestros órganos expuestos e incluso nuestro interior. De hecho, el peso total de las bacterias con las que convivimos puede variar entre los 900gr y los casi 2 kilos. Sí, dos kilos de microbios. Estos son especialmente abundantes, cómo no, en el colon, donde suponen casi el 50% del peso seco. Estas bacterias con las que convivimos normalmente son conocidas como microbiota (normal) o microbioma. Esta palabra no quiere decir otra cosa que "conjunto de ecosistemas" y hace referencia a las relaciones de vecindad que hacen los microorganismos en nuestro cuerpo, como si cada uno de nosotros se tratase de un pequeño planeta. Bien.
Como identificación personal
El microbioma contiene un conjunto de bacterias. El cuerpo humano suele albergar unas 2.000 especies distintas de microorganismos. El conjunto de cada microbiota es característico de cada persona y situación. Depende de la alimentación, el estado de salud o incluso el estrés de la persona. Podemos identificar a una persona por su microbioma. En concreto, un grupo de investigadores ha encontrado la forma de usar el genoma de los microorganismos para hacer un perfil del microbioma procedente de la saliva, la piel o las heces como una posible herramienta forense.
Aunque el estudio microbiológico de los organismos que viven en nuestro cuerpo es relativamente nuevo (como ecosistema, quiero decir) existe toda una fiebre al respecto. De pronto, todo, y digo todo, tiene que ver con el microbioma. Desde las enfermedades al estado de ánimo, pasando por cualquier otro aspecto de la salud.
El microbioma se encarga de procesar gran parte de nuestros alimentos en el intestino, producir ácidos grasos y vitaminas que nosotros no podemos sintetizar e, incluso, combatir contra otros organismos que intentan infectarnos. El desajuste del microbioma provoca numerosas de las patologías que nos afectan. Por ello, reestablecer o sustituir un microbioma deficiente o "roto" es una manera de tratar ciertas enfermedades. O al menos esa es la hipótesis. Hasta el momento las pruebas, tanto con dientes como con intestino han funcionado muy bien.




